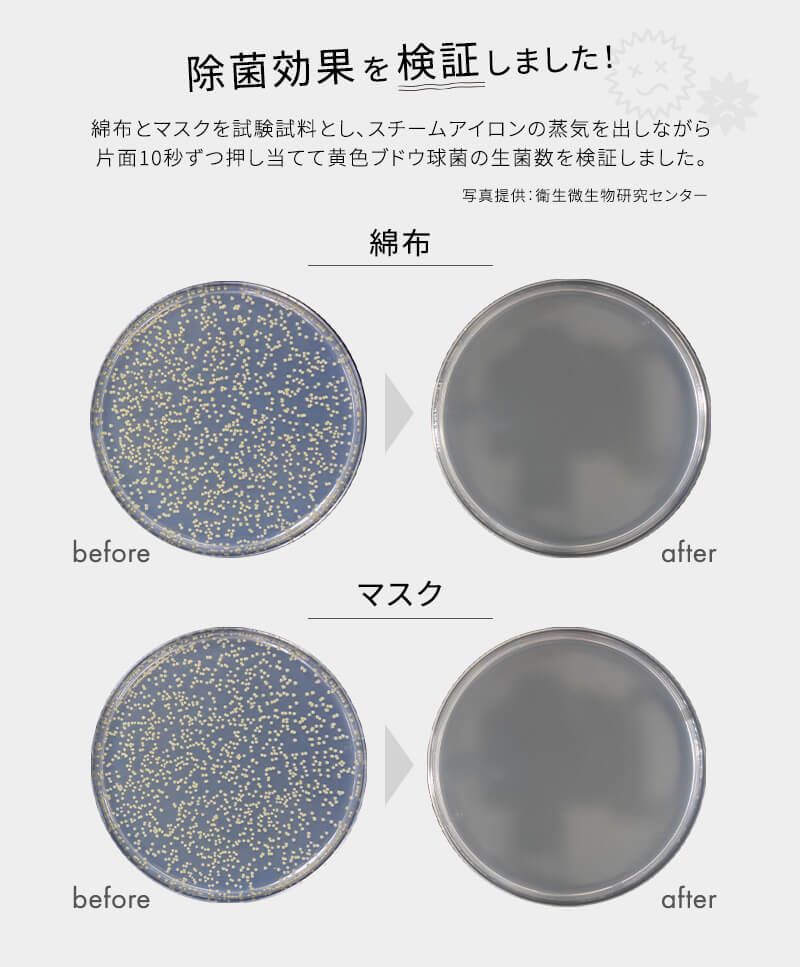

KALOS BEAUTY TECHNOLOGY RM-SS401-P ピンク [衣類スチーマー]
噴射量の大きい高温ジェットスチームで瞬間シワ伸ばし。
商品コード:202915404625001 |
- 商品状態
- 新品
- 価格
-
¥ 8,780 (税込)
- 送料無料
- ポイント
- 87ポイント(1%) (¥87相当)
- 詳細はこちら
- 配送目安
-
- 通常 2026年05月03日(日)まで に出荷

br />
br />

★ これ1つで、除菌・消臭・シワ伸ばし・花粉除去など、毎日のあらゆる場面で大活躍。
※全ての菌を除菌するわけではありません。
★ 高温スチームで除菌!マスク不足の解消にも。
★ アイロンとしても使える便利な2Way。
★ 使い方も片づけもラクラク。
| 基本仕様 | |
|---|---|
| タイプ | スタイリッシュスチーマー |
| ハンガーアイロン(ハンガーショット) | ○ |
| オートオフ | |
| プレス機能 | あり |
| 海外対応 | |
| 全方位対応 | |
| 立ち上がり時間 | |
| 折りたたみ | ○ |
| かけ面温度調節 | |
| かけ面素材 | フッ素系 |
| 消費電力 | 1000W(定格消費電力) |
| 収納ケース(袋) | |
| スチーム機能 | |
| 水タンク容量 | 140 ml |
| スチーム温度調節 | |
| スチーム量 | 最大25g/分 |
| スチーム持続時間 | |
| カセット式給水タンク | ○ |
| スプレー | |
| 脱臭 | |
| 除菌 | ○ |
| 水漏れ防止 | |
| コード | |
| コードタイプ | コード有り |
| コード長さ | 1.9 m |
| コードリール式 | |
| コードリール式(置き台) | |
| サイズ・重量 | |
| 外形寸法/本体寸法 | |
| 重量 | 0.75 kg |
-
No.1
![PANASONIC NI-FS60B-G セージグリーン [衣類スチーマー] PANASONIC NI-FS60B-G セージグリーン [衣類スチーマー]](//pics.xprice.co.jp/i/2900/0-4549980882900M.jpg)
PANASONIC NI-FS60B-G セージグリーン [衣類スチーマー]
¥ 8,980(税込)
在庫有り(本日千葉物流センターより出荷)
送料: 無料
一緒に買う -
No.2
![PANASONIC NI-FS60B-A カームネイビー [衣類スチーマー] PANASONIC NI-FS60B-A カームネイビー [衣類スチーマー]](//pics.xprice.co.jp/i/2894/0-4549980882894M.jpg)
PANASONIC NI-FS60B-A カームネイビー [衣類スチーマー]
¥ 9,396(税込)
在庫有り(本日千葉物流センターより出荷)
送料: 無料
一緒に買う -
No.3
![東芝 HIP-T36-S シルバー [ズボンプレッサー(スタンド型)] 東芝 HIP-T36-S シルバー [ズボンプレッサー(スタンド型)]](//pics.xprice.co.jp/i/2503/4904550962503M.jpg)
東芝 HIP-T36-S シルバー [ズボンプレッサー(スタンド型)]
¥ 19,600(税込)
7営業日以内に出荷
送料: 無料
一緒に買う -
No.4
![東芝 TA-FV470-R マルーンレッド La・Coo ラウンド美ラクルベース [コードレススチームアイロン] 東芝 TA-FV470-R マルーンレッド La・Coo ラウンド美ラクルベース [コードレススチームアイロン]](//pics.xprice.co.jp/i/9100/4904530129100M.jpg)
東芝 TA-FV470-R マルーンレッド La・Coo ラウンド美ラクルベース [コードレス...
¥ 6,280(税込)
7営業日以内に出荷
送料: 無料
一緒に買う




![PANASONIC NI-FS60B-G セージグリーン [衣類スチーマー] PANASONIC NI-FS60B-G セージグリーン [衣類スチーマー]](http://pics.xprice.co.jp/i/2900/0-4549980882900M.jpg)
![PANASONIC NI-FS60B-A カームネイビー [衣類スチーマー] PANASONIC NI-FS60B-A カームネイビー [衣類スチーマー]](http://pics.xprice.co.jp/i/2894/0-4549980882894M.jpg)
![東芝 HIP-T36-S シルバー [ズボンプレッサー(スタンド型)] 東芝 HIP-T36-S シルバー [ズボンプレッサー(スタンド型)]](http://pics.xprice.co.jp/i/2503/4904550962503M.jpg)
![東芝 TA-FV470-R マルーンレッド La・Coo ラウンド美ラクルベース [コードレススチームアイロン] 東芝 TA-FV470-R マルーンレッド La・Coo ラウンド美ラクルベース [コードレススチームアイロン]](http://pics.xprice.co.jp/i/9100/4904530129100M.jpg)
















